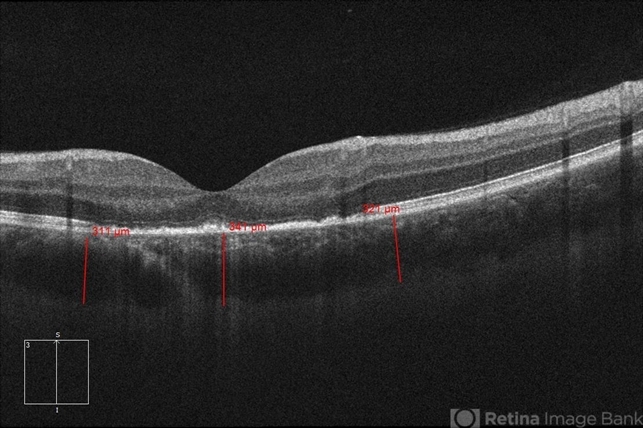

-
 By Hosam Attia, MD
By Hosam Attia, MD
- Uploaded on Jul 24, 2018.
- Last modified by Caroline Bozell on Jul 24, 2018.
- Rating
- Appears in
- Unilateral Acute Idiopathic Maculopathy (UAIM)
- Condition/keywords
- unilateral acute idiopathic maculopathy
- Imaging device
-
Optical coherence tomography system
Zeiss-Cirrus 4000 - Description
- 20-year-old white, male presented for initial evaluation with one week history of acute, sudden, painless loss of central vision in his right eye a week prior to presentation. - H/O short course of exogenous testosterone, Tamoxifen and Clomiphene intake ~ 2-3 weeks cycle, which was already stopped, prior to development of pt's symptoms. - H/O acute illness with generalized fatigue, malaise, URTI like symptoms and rash over the hands and chest, just prior to symptoms development, and upon further discussion, pt mentioned that few of his friends got sick around the same time. - Patient was seen the week prior by general ophthalmologist and was found to have SRF on OCT , diagnosed with CSCR and referred for retina evaluation. - ROS/ PMHx: Negative, healthy aside from the short illness described above - Denied any prior vision problems, similar episodes, trauma etc - VA Dsc OD: 20/400 OS:20/20 - anterior segment exam - unremarkable - posterior segment - macular RPE changes/ clumping with GA with no CME/ SRF or crystals OD, and unremarkable OS. - Pseudocolor and FAF photos: RPE changes/ clumps w/ GA and stippled autofluorescense OD, unremarkable OS. - HD SD-OCT: thickened choroid, thickened/ hypertrophied subfoveal RPE with hyper-reflective material on the apical side of the retinal pigment epithelium/apical debris, Subfoveal ellipsoid zone atrophy w/ intact ELM W/No CME or SRF OD, Unremarkable OS. - FA: Dye not available - ICG: deferred - mf-ERG & VF - patient rescheduled

Initializing download.
Initializing download.










